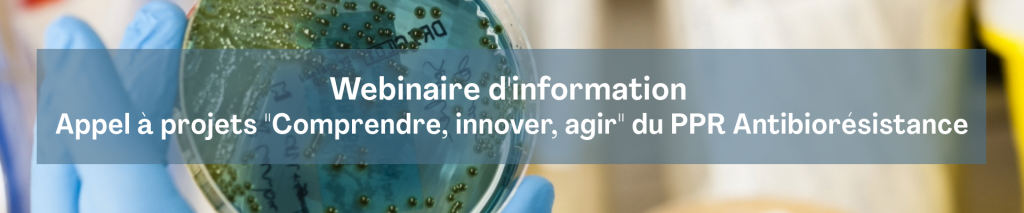

Le PPR Antibiorésistance lance un second appel à projets “Comprendre, innover, agir” doté de 2M€. L’appel se déroule du 8 janvier 2026 au 14 avril 2026.
L’ANR, en charge de cet appel, organise un webinaire d’information le 9 mars 2026, de 14h à 15h30.
Ce webinaire vise à présenter le contexte et les enjeux du PPR Antibiorésistance, ainsi que les objectifs de cet appel. Les critères de recevabilité, les modalités de soumission et le calendrier seront détaillés. La session se conclura par un temps d’échanges afin de répondre aux questions des participants.